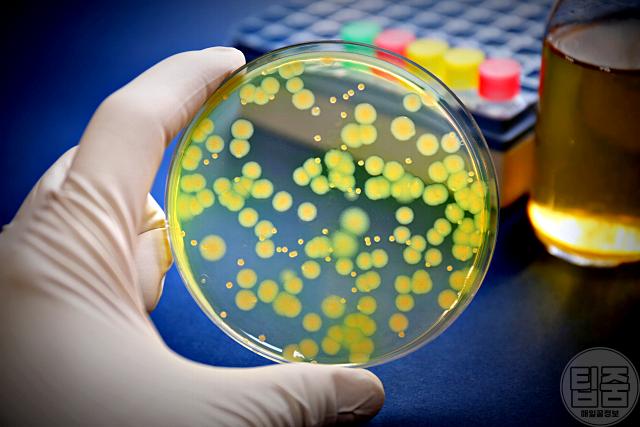
리필용기 세척 녹농균 항생제 내성

샴푸, 액체비누, 화장품, 향수 등 리필 제품은 경제적이고 쓰레기 감소에도 도움돼 많이들 사용하실텐데요. 근데 리필용기 세척 후 사용하는 분들은 있지만, 세척 후 '이것' 은 안하고 사용하는 경우가 적지 않다는데요. 잘못되면 폐혈증 걸릴 수 있답니다. 녹농균 (Pseudomonas aeruginosa) 때문인데요.
1. 녹농균이란?

녹농균은 증식 조건이 까다롭지 않은 세균으로, 영양분이 부족한 환경에서도 수분만 있으면 빠르게 증식하는 특성을 가지고 있습니다. 화장실, 욕조, 온천 등 습기 많은 곳에서 쉽게 발견되는데, 우리가 매일 사용하는 샴푸 액체비누 용기 속에서도 증식할 수 있어요.
문제가 되는 건 녹농균의 강한 항생제 내성입니다. 면역력 약한 어린이 노인, 수술 후 저항력 떨어진 사람이 감염되면, 피부 조직 손상, 고름, 통증, 오한, 발열, 두통 등 다양한 증상을 유발한다고 해요. 건강한 사람도 축농증, 요도염, 전립선염, 모낭염을 유발할 수 있고, 심할 경우 폐렴 및 폐혈증으로 생명을 위협할 수도 있죠.
2. 리필용기 세척 후 '이것' 녹농균 예방해요

리필용기 세척 후 반드시 해야 하는 것 바로 "완전 건조" 입니다. 녹농균은 건조에 약한 세균 이기 때문이에요. 그래서 녹농균 감염 예방을 위해 리필용기 재사용은 아래과 같은 관리가 필요해요.

- 리필 전 남아 있는 잔여물을 깨끗이 씻어내요.
- 세척 후 용기를 완전히 말려 습기를 없애야 합니다.
- 오래된 용기는 교체하는 것이 안전해요.

리필용기 세척은 해도, 건조는 안하고 그대로 사용했던 분들 있을실텐데요. 녹농균은 적은 습기만 있어도 왕성한 증식을 할 수 있답니다. 완전히 '건조' 후에 사용하는것 잊지마세요. 건강하세요. 감사합니다.^^
좋았다면 ♡공감 꾹!
※ 복사 재배포 금지
